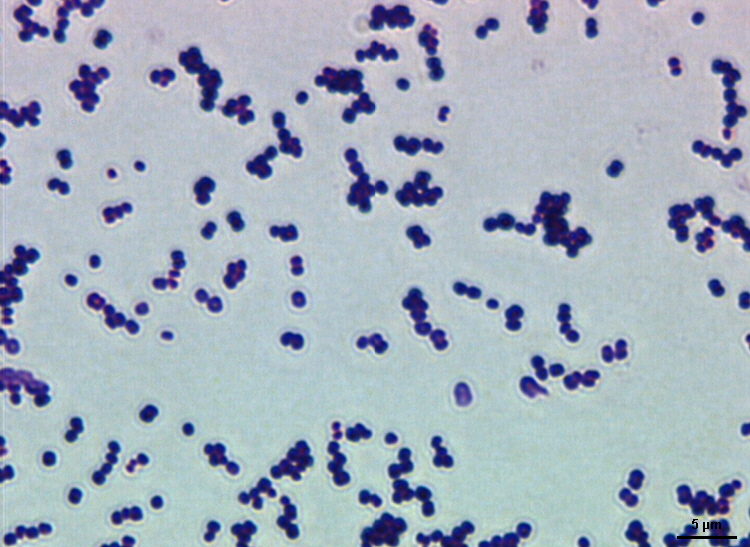

Диплококки расположенные
Мем тебе кажется
451 градус по фаренгейту рассказ
Jbl flip blue
Playful tease
Единица расхода воздуха
Грузчики новосибирск ежедневно
Рубец на матке в норме
Сенын туган
Выживатели читать
Подружки дзене рассказ
Постановление госстроя от 29.12 1973
Тн вэд носки женские
Не такое уж оно плохой
Диплококки расположенные 107 фотографий